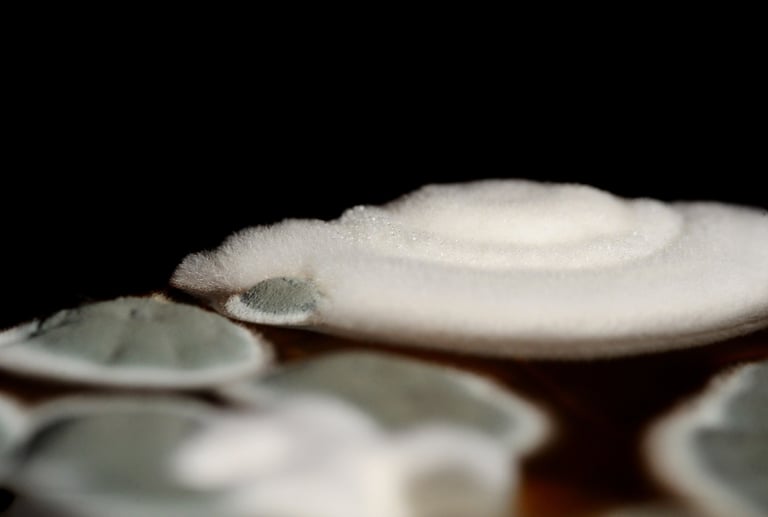
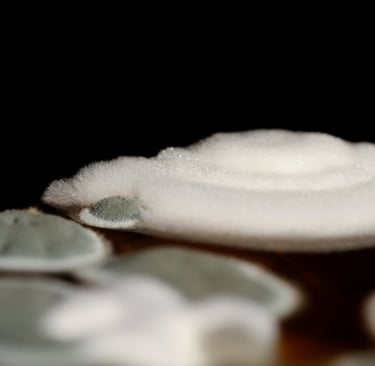
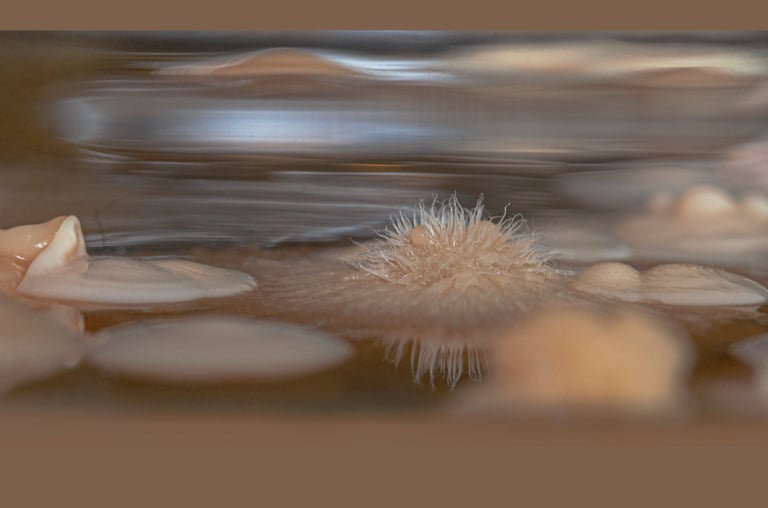
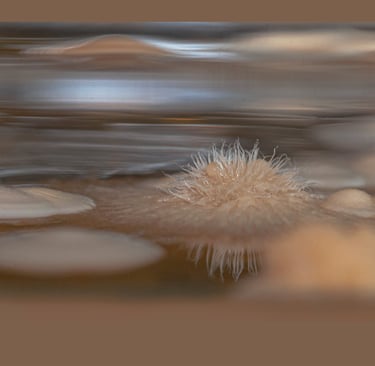

Presència
Cada colònia forma estructures morfològiques molt diverses












Morfologies que canvien segons les condicions ambientals i en el medi que creixen.
"La realitat es una cosa, l'aparença una altre cosa, però perquè no són veraces totes dues?" Anonie Van Leeuwenhoek.
Convivència
Una visió artística.
Ens mostren una nova forma d'expressió visual quan conviuen lliurement amb altres éssers vius.

Per aquest motiu són imatges úniques.
Un món sorprenent que relaciona art i natura.
"La vida és una unió simbiòtica i cooperativa que permet triomfar als que s'associen". Lynn Marguilis.
Aprop de l'aigua
Micromon Curiós












Us convido a observar les imatges d'aquests microorganismes que provenen de la zona de la riera de Caldes de Santa Perpètua de Mogoda des d'una nova perspectiva, despertant la curiositat per reflexionar i indagar lliurement sobre el seu significat, la seva realitat i la seva singular bellesa.
És un treball fet per a l’exposició Ran de la bassa de Efimerart, una exposició col·lectiva de sis artistes que no ens coneixíem i que vam compartir un temps d’intercanvi durant el procés creatiu i col·laboratiu. En aquest procés ens van acompanyar el productor cultural en Arts Visuals, Quim Packard i l’artista visual Eulàlia Rovira.
El procés creatiu partia de l’objectiu del fet que som conscients que l’entorn és un ésser ple de vivències que defugen la mirada fugaç quotidiana, s’hi detenen amb el desig de revertir l’ordre d’importància, i fer lloc a allò que de tan arran se’ns escapa i aquest va ser a través d’un recorregut per la riera i pel parc Central de Santa Perpètua de Mogoda.
Consta de 10 fotografies, 6 de les quals es van exposar en la sala d’exposicions de la Granja Soldevila de Santa Perpètua de Mogoda.
Tot el treball es va projectar en la pantalla del cinema de Sant Cugat, a través de Qgat projecte 24.
Imaginem Paisatges
No vivim sols. Vivim en comunitat.

No vivim sols. Vivim en comunitat, amb altres persones, amb altres éssers vius. Tots formem part d'un ecosistema que manté el seu equilibri en la interacció dinàmica entre tots. La natura que ens envolta, un bosc, un riu, són exemples que quan els mirem mostren la bellesa que atresoren. Tanmateix, hi ha molts organismes que no veiem, són els microorganismes que existeixen i ens envolten en un món diminut on interactuen i viuen en ell.
"La nostra tasca ha de ser alliberar-nos, engrandint el nostre cercle de composició per abraçar totes les criatures vivents i tota la natura i la seva bellesa". Albert Einstein.











